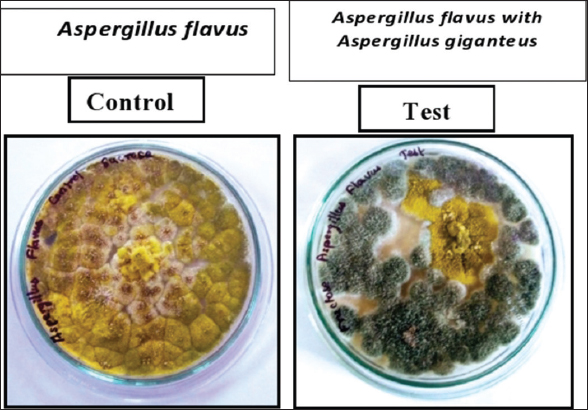

1. INTRODUCTION
Fungi are eukaryotic organisms that are ready to grow on any kind of surface and infect almost any multicellular organisms. They are the foremost decomposers and they can easily infect various types of organisms. More than 400 fungal species in the environment end up in harmful effects to plants and human [1]. Fungi cause both endemic and severe infections, predominantly in the immune-compromised and debilitated host [2]. Invasive fungal infections such as invasive aspergillosis remain a leading source of dreariness and mortality [3]. Contagious parasitic strains such as the Aspergillus flavus, Candida albicans, Aspergillus fumigatus, and Cryptococcus neoformans cause serious infections [4]. A. flavus is the next major one and causes maximum invasive and superficial infections in humans. A. flavus is a xerophilic fungus that has evolved mechanisms of physiological action versus to environmental strain elements letting them compete and frequently dominates with different fungal communities [5]. A. flavus infection is common in Asia, the Centre East, and Africa, possibly due to its superior ability to survive in hot and arid climates in comparison with other Aspergillus spp. In humans, A. flavus causes clinical syndromes similar to A. fumigatus [6]. It can colonize organs driving to conditions such as keratitis, cutaneous contaminations, sinusitis, and obtrusive pulmonary aspergillosis [7]. A. flavus infection leads to both surgical and non-surgical fungal rhinosinusitis. Acute surgical fungal rhinosinusitis is a rare, but rapidly progressive lethal disease with 20–80% death rates. Antifungals are the most commonly used drugs for the treatment and prophylaxis of wider fungal diseases which include polyenes, azoles (triazoles and imidazoles), echinocandins, and pyrimidine analogs. They have a spectrum of activity and diverse modes of action [8]. Actuation of multi drug resistance protein that pumps out antifungal drugs from the location of the target has been detailed. In this way, the part of efflux pump in azole resistance might be one of the reasons for treatment disappointment in aspergillosis cases [9]. Only some categories of antifungal agents are accessible today, and the development of resistance has decreased the efficacy and increased host toxicity undesirable side effects. Therefore, an alternative compound should be developed with properties and mechanisms of action representing the superior to the existing ones. Subsequently, the hunt for modern antifungals that specifically hinder the spore germination of contagious pathogens without influencing people and environment is of most extreme significance. Fungi are a momentous asset for creating novel antifungal metabolites. Here, antifungal proteins (AFPs) of the AFP family are of extraordinary intrigued [10]. Fungi have a diverse set of AFPs that vary in amino acid composition and sequence. AFPs have already been shown to be toxic to some of the most dangerous mycotoxin-producing fungi [11]. AFP from Aspergillus giganteus selectively inhibits the growth of filamentous fungi without affecting the feasibility of the mammalian, plant, or bacterial cells. AFPs are, moreover, characterized by their intemperate viability and steadiness. In this way, AFP can serve as a lead compound for the advancement of novel antifungals [12]. To understand the antagonistic efficacy of the A. giganteus against pathogenic fungi, the study was focused on the mode of action of AFP from A. giganteus and the optimization of culture conditions for its influence on antagonistic potential.
2. MATERIALS AND METHODS
2.1. Test Microorganisms and their Maintenance
The fungal strain of A. giganteus was purchased from MTCC – IMTECH Chandigarh and the strain number is MTCC 8408. The pathogenic fungi A. flavus was obtained from PSGIMS, Coimbatore. The subculture of the antagonist and pathogenic fungi was maintained in Czapek basal media.
2.2. Dual Culturing
A dual culture system is an effective test to identify the interactions of antagonistic fungi with pathogenic fungi. 5 mm diameter of actively grown mycelia from antagonistic fungi A. giganteus and pathogenic fungi A. flavus were inoculated on Petri plates containing czapek yeast extract agar. Both agonist and pathogenic fungi grow in opposite directions at equal distances from each other. The mycelia from pathogenic fungi inoculated in the plate in the absence of A. giganteus was used as a control. Then, the plates were incubated at 28°C for 4–6 days. The percentage of radial inhibition was calculated.
The percentage of inhibition was expressed by following equation:
 |
Where,
Control = growth of fungal pathogen
Test = growth of the fungal pathogen in the presence of antagonistic fungi.
Interaction ranked according to the Bell ranking scale [13].
2.3. Hyphal Interaction Assay
Hyphae is a long branching filamentous structure of fungi. It is the main mode of vegetative growth and is collectively called mycelium. The hyphae of the pathogenic fungi usually undergo modification in the presence of antifungal compounds. The hyphae can be viewed by different staining processes. In our study, the hyphal interaction assay using lactophenol cotton blue staining was carried out to further confirm the antifungal activity of A. giganteus. Briefly, a drop of lactophenol cotton blue was placed on a clean glass slide. Transferred a loop of fungus usually with spores and spore-bearing structure into the broth using a flamed needle. Mixed gently the stain with the mold structures. Placed a coverslip over the preparation and examined it under the microscope [14].
2.4. Evaluation of the Antagonistic Effect of A. giganteus with Different Environmental Conditions
The antagonistic efficacy of A. giganteus against A. flavus might vary based on the culture conditions which could influence antifungal activity. To evaluate that, the culturing of A. giganteus was optimized in varying the pH, temperature, carbon, and nitrogen sources. To determine the antagonistic efficacy of antagonist fungi, a co-culture assay was performed in the same manner as the dual culture assay. Different carbon sources, such as sucrose, fructose, with 3%, maltose, and dextrose with 2% were chosen to evaluate the competition between A. giganteus and A. flavus for survival. Similarly, co-culture was performed with different nitrogen sources such as ammonium sulfate and ammonium dihydrogen orthophosphate. The control, test plates were incubated at 28°C for 4–5 days, and then, the mycelial radial growth was measured. The pH of the medium plays a major role in altering antifungal activity. Hence, czapek basal media with a different pH range of 5, 6, and 7 was prepared and the antagonistic efficacy of A. giganteus was assessed. The control and test plates were incubated at 28°C for 4–5 days, and then, the mycelial radial growth was measured. To optimize the temperature for the increased level of inhibition by A. giganteus, co-culturing of the antagonistic and pathogenic fungi (A. flavus) was carried out in czapek basal media and incubated at different temperatures chosen (28°C, 30°C, and 35°C) for 4 days. The radial growth of A. flavus in control plates and test in dual culture was measured and percentage growth inhibition was calculated for the triplicates [15].
3. RESULTS AND DISUSSION
Fungal diseases are considered as the major danger to human wellbeing and lead to the most noteworthy mortality and dreariness rate around the world. Major parasitic pathogens are known to cause the harmful impact to plants, creatures, human, and environment when it gets to be weakened or immunocompromised [16]. The plant metabolites are well known potential compounds for the treatment of different bacterial and parasitic pathogens. Other than the various sources, filamentous fungi can act as a valuable source for the generation of antifungal compounds showing enmity against different contagious and bacterial pathogen filamentous known potential compounds for the treatment of different bacterial and parasitic pathogens [17]. A. giganteus may be a filamentous organism, known to create AFP and a few logical shreds of prove too claimed that the AFP is discharged by the A. giganteus [18-20].
From the results, the inhibition of A. flavus by A. giganteus was found to be 84% in dual culture assay. The growth of A. flavus was arrested by the antifungal compounds released by A. giganteus. The inhibitory effect of A. giganteus on A. flavus is shown in Figure 1. Further, the hindrance intervened by A. giganteus was analyzed infinitesimally with lactophenol cotton blue staining. A. flavus developed within the nearness of A. giganteus appeared diminished hyphal stretching when compared with the control which shown a much more amplified mycelium. In addition, the tips of the hyphae showed up swollen proposing that the extremity of the hyphal tip was influenced by A. giganteus the inhibition mediated by A. giganteus was analyzed microscopically with lactophenol cotton blue staining. A. flavus grown in the presence of A. giganteus showed reduced hyphal elongation when compared with the control which displayed a much more extended mycelium. Moreover, the tips of the hyphae appeared swollen suggesting that the polarity of the hyphal tip was affected by A. giganteus, as shown in Figure 2.
| Figure 1: Dual culture assay of Aspergillus giganteus and Aspergillus flavus, the Control plate shows a complete growth of Aspergillus flavus, whereas, in the test plate, the mycelia of Aspergillus flavus was surrounded by Aspergillus giganteus. By measuring the radial growth of the mycelia test plates shows a high level of inhibition by Aspergillus giganteus. [Click here to view] |
 | Figure 2: Hyphal interaction assay. In normal condition, the hyphae of Aspergillus flavus was long and extended, whereas, in the co-culture condition in the presence of Aspergillus giganteus, the hyphal compartments were swollen in a polar manner, resembling pearls on a string. [Click here to view] |
In agreement with the present studies, the dual culture strategy has been broadly connected in enmity studies since this investigation encourages the in-vitro screening of operators that can be utilized for natural control [21]. The antagonistic ability of two Trichoderma species against different fungal pathogens, namely, Aspergillus niger, Penicillium cyclopium, and two Fusarium species was investigated, where Trichoderma harzianum had the maximum inhibiting effect on the growth of fusarium species (71%) and Penicillium cyclopium (42.8%), respectively [22].
The antagonistic effect of A. giganteus causes structural modification in hyphae during the dual culture assay. The changes in hyphal morphology could be a strong evidence that supports the effect or level of antagonistic effect of A. giganteus. In a study conducted by Xing et al., [23] the fungicidal effect of chitosan against Ceratocystis fimbriata was evaluated by the hyphal interaction assay. C. fimbriata hyphae exhibited characteristic healthy morphology in the absence of chitosan, whereas degenerative alterations in the hyphal morphology were observed after chitosan treatment. Hyphae showed irregular bending and uneven staining. Structural changes like swollen orbicular structure called theca were observed on the fungal mycelia head with the thickening of the hyphae on interaction with Bacillus subtilis and Tamarindus indica [24].
A similar study conducted by Cherkupally et al. [25] evaluated the antagonistic efficacy of Trichoderma spp. against Fusarium oxysporum by bio-control assays such as dual culture and further proved by hyphal interaction assay. The hyphae of the pathogens were shrunken and lead to lysis. These investigations have demonstrated that antifungal compounds largely influence the structural shape of fungal pathogens, hence slowing their proliferation.
3.1. Optimization of the Culture Conditions
The medium-independent antagonism was determined with different carbon sources such as sucrose, fructose, maltose, and dextrose. Among the various sources used, dextrose as a carbon source used in czapek media showed a higher degree of inhibition and the results are shown in Figure 3.
 | Figure 3: Percentage inhibition of Aspergillus giganteus on Aspergillus flavus during co-culture in various carbon sources. Co-culture of Aspergillus giganteus and Aspergillus flavus in the Czapek medium with different carbon sources. The maximum inhibition of 84% was seen for co-culture done with dextrose as the carbon source. With sucrose, fructose, and maltose the percentage of inhibition is less compared to dextrose. [Click here to view] |
The antagonist activity of A. giganteus was elevated and attained its maximum inhibition in the czapek medium with dextrose as carbon sources, compared to sucrose, fructose, maltose, and dextrose incorporated czapek media was chosen for further studies. In the co-culture assay carried out with the different nitrogen sources, the impact of antifungal metabolite on the growth arrestment of pathogenic fungi was considerably high in the czapek medium with ammonium dihydrogen phosphate as the nitrogen source [Figure 4].
 | Figure 4: Percentage inhibition of Aspergillus giganteus on Aspergillus flavus during co-culture in various nitrogen sources. Co-culture of Aspergillus giganteus and Aspergillus flavus in the Czapek medium with different Nitrogen sources. In this, Ammonium di-hydrogen orthophosphate shows a maximum inhibition of 84% compared with others used. [Click here to view] |
In case of varying pH, the release of the antifungal metabolite from antagonistic fungi was favored at pH 7.0 to that of pH 5 and 6, as depicted in Figure 5. The optimum temperature for the increased antagonistic activity was derived from co-culturing the antagonistic and pathogen at different temperatures. In comparison with the different temperatures, 28°C, 30°C, and 35°C, A. giganteus had shown a higher degree of inhibition on the pathogen at 28°C, as shown in Figure 6.
 | Figure 5: Percentage inhibition of Aspergillus flavus during co-culture with Aspergillus giganteus in czapek medium with different pH. [Click here to view] |
 | Figure 6: Percentage inhibition of Aspergillus giganteus on Aspergillus flavus during culture in different temperature. In czapek medium with different temperature, the antagonistic effect of Aspergillus giganteus was found to be significant in the plate incubated at 28°C. It is depicted that the antagonistic effect is higher at 28°C compared to that of the other two temperature conditions 30°C and 35°C. [Click here to view] |
In a study conducted by Yang et al., [26] the role of fermentation conditions for amoxicillin degrading bacteria was investigated, including inoculum level, fermentation time, temperature, pH, and shaker speed. Among the variables tested, pH, fermentation time, and inoculum level all had a significant impact on the growth of the screened bacterial strain. The optimal fermentation conditions were pH 6.9, fermentation time 52.1 h, and inoculum level of 2%. Bacterial growth rate was increased by 67.6% under optimal conditions.
With regard to the impacts of different C/N proportions with four basic microelements on contagious morphological separation, AFP generation was examined in submerged aging of A. giganteus MTCC 8408. Proportion of K+/Ca2+ played a major part in endogenous cell separation and improved AFP generation [27].
Three microelements interaction with a physical factor in the cell wall immaturity and hyphae branching was investigated, in which pH had a significant impact on cell morphology. Cacl2 had the greatest influence on AFP production at the individual level, followed by pH. When compared to basal Olson medium, mycelial biomass was increased by 1.22 times and AFP production was increased by 2.21 times, indicating that the optimal conditions could increase the rate of biomass and AFP production [28].
In this study, the various culture conditions for the increased antagonistic efficacy of A. giganteus against A. flavus were determined. The dual culturing of the antagonistic and the pathogenic fungi indicated that the antifungal metabolite released from A. giganteus retarded the growth of the pathogen. The hyphae of fungal pathogen played an important role in the process of infection. The hyphal morphological changes in A. flavus during the co-culture with A. giganteus further proved that the A. giganteus releases the antifungal metabolite which could able to bring the structural changes at the molecular level and inhibits the growth of the pathogen. Further from the optimization of culture conditions, the antagonistic potential of AFP was highly influenced by different carbon and nitrogen sources, different pH, and temperature at different range.
4. CONCLUSION
The study has proved that the environmental conditions play a key role in the level antagonistic efficacy of A. giganteus. It clearly depicts that at the optimal culture conditions, we conclude that the antifungal metabolite from the fungal source has a strong antagonistic activity against human fungal pathogens. Hence, the antifungal metabolite from the A. giganteus can be purified and can be developed as a novel drug to treat infections like Aspergillosis and can be scaled up to large scale production with the optimal condition.
5. AUTHORS’ CONTRIBUTIONS
All authors made substantial contributions to conception and design, acquisition of data, or analysis and interpretation of data; took part in drafting the article or revising it critically for important intellectual content; agreed to submit to the current journal; gave final approval of the version to be published; and agreed to be accountable for all aspects of the work. All the authors are eligible to be an author as per the International Committee of Medical Journal Editors (ICMJE) requirements/guidelines.
6. FUNDING
There is no funding to report.
7. CONFLICTS OF INTEREST
The authors report no financial or any other conflicts of interest in this work.
8. ETHICAL APPROVALS
This Study doesn’t involves experiments on animals or humans.
9. DATA AVAILABILITY
All data generated during the current study are included in this article.
10. PUBLISHER’S NOTE
This journal remains neutral with regard to jurisdictional claims in published institutional affiliation.
REFERENCES
1. Hyde KD, Xu J, Rapior S, Jeewon R, Lumyong S, Niego AG, Stadler M. The amazing potential of fungi:50 ways we can exploit fungi industrially. Fungal Divers 2019;97:1-136. [CrossRef]
2. Li Z, Lu, Meng G Pathogenic fungal infection in the lung. Front Immunol 2019;10:1524. [CrossRef]
3. Donnelly JP, Chen SC, Kauffman CA, Steinbach WJ, Baddley JW, Verweij PE, et al. Revision and update of the consensus definitions of invasive fungal disease from the European Organization for Research and Treatment of Cancer and the Mycoses Study Group Education and Research Consortium. Clin Infect Dis 2020;71:1367-76. [CrossRef]
4. Gnat S, ?agowski D, Nowakiewicz A, Dyl?g M. A global view on fungal infections in humans and animals:Opportunistic infections and microsporidioses. J Appl Microbiol 2021;131:2095-113. [CrossRef]
5. Medina A, Gilbert MK, Mack BM, OBrian GR, Rodriguez A, Bhatnagar D, et al. Interactions between water activity and temperature on the Aspergillus flavus transcriptome and aflatoxin B1 production. Int J Food Microbiol 2017;256:36-44. [CrossRef]
6. Rudramurthy SM, Paul RA, Chakrabarti A, Mouton JW, Meis JF. Invasive aspergillosis by Aspergillus flavus:Epidemiology, diagnosis, antifungal resistance, and management. J Fungi (Basel) 2019;5:55. [CrossRef]
7. Plabutong N, Ekronarongchai S, Niwetbowornchai N, Edwards SW, Virakul S, Chiewchengchol D, et al. The inhibitory effect of validamycin A on Aspergillus flavus. Int J Microbiol 2020;2020:3972415. [CrossRef]
8. Kara TT, Ciftci E, Ar?soy ES. Antifungal agents for pediatric ear, nose, and throat infections. In:Pediatric ENT Infections. Cham:Springer;2022. 1031-41. [CrossRef]
9. Shishodia SK, Tiwari S, Shankar J. Resistance mechanism and proteins in Aspergillus species against antifungal agents. Mycology 2019;10:151-65. [CrossRef]
10. Utesch T, de Miguel Catalina A, Schattenberg C, Paege N, Schmieder P, Krause E, et al. A computational modeling approach predicts interaction of the antifungal protein AFP from Aspergillus giganteus with fungal membranes via its g-core motif. mSphere 2018;3:e00377-18. [CrossRef]
11. Martínez-Culebras PV, Gandía M, Garrigues S, Marcos JF, Manzanares P. Antifungal peptides and proteins to control toxigenic fungi and mycotoxin biosynthesis. Int J Mol Sci 2021;22:13261. [CrossRef]
12. Gandía M, Kakar A, Giner-Llorca M, Holzknecht J, Martínez-Culebras P, Galgóczy L, et al. Potential of antifungal proteins (AFPs) to control Penicillium postharvest fruit decay. J Fungi 2021;7:449. [CrossRef]
13. Bell DK, Wells HD, Markham CR. In vitro antagonism of Trichoderma species against six fungal plant pathogens. Phytopathology 1982;72:379-82. [CrossRef]
14. Wilkes TI, Warner DJ, Edmonds-Brown V, Davies KG, Denholm, I. A comparison of methodologies for the staining and quantification of intracellular components of arbuscular mycorrhizal fungi in the root cortex of two varieties of winter wheat. Access Microbiol 2020;2:acmi000083. [CrossRef]
15. Krishnamurthy R, Padma P, Dhandapani K. Antagonistic efficiency of Aspergillus giganteus as a biocontrol agent against aflatoxigenic Aspergillus flavus infecting maize. J Pure Appl Microbiol 2020;14:527-39. [CrossRef]
16. Lozano VH, Rangel TR, Gonzalez GM, Rodriguez PA, Ortiz CA, Reyna CL, et al. Clinical evaluation of the antifungal effect of sertraline in the treatment of cryptococcal meningitis in HIV patients:A single Mexican center experience. Infection 2018;46:25-30. [CrossRef]
17. Fisher MC, Gurr SJ, Cuomo CA, Blehert DS, Jin H, Stukenbrock EH, et al. Threats posed by the fungal kingdom to humans, wildlife, and agriculture. Am Soc Microbiol 2020;11:1-17. [CrossRef]
18. Vila L, Lacadena V, Fontanet P, Pozo AM, Segundo BS. A protein from the mold Aspergillus giganteus is a potent inhibitor of fungal plant pathogens. Am Phytopathol Soc 2001;14:1327-31. [CrossRef]
19. Bondaryk M, Staniszewska M, Zielinska P, Lipkowska ZU. Natural antimicrobial peptides as inspiration for design of a new generation antifungal compounds. J Fungi 2017;3:1-36. [CrossRef]
20. Theis T, Wedde M, Meyer V, Stahl U. The antifungal protein from Aspergillus giganteus causes membrane permeabilization. Antimicrob Agents Chemother 2003;47:588-93. [CrossRef]
21. Orlandelli RC, Almeida TT, Alberto RN, Polonio JC, Azevedo JL, Pamphile JA. Antifungal and proteolytic activities of endophytic fungi isolated from Piper hispidum Sw. Braz J Microbiol 2015;46:359-66. [CrossRef]
22. Arya R. Antagonistic activity of two Trichoderma species against few phytopathogenic fungi. Comparing Antagonistic Activity of two Trichoderma Species against Fusarium Wilt in Tomato;2018.
23. Xing K, Li TJ, Liu YF, Zhang J, Zhang Y, Shen XQ, et al. Antifungal and eliciting properties of chitosan against Ceratocystis fimbriata in sweet potato. Food Chem 2018;268:188-95. [CrossRef]
24. Asthana S, Vajpayee G, Sundaram S. Evaluation of antagonist potential of Bacillus spp. against plant pathogenic fungus. Indian J Nat Sci 2016;6:10996-1003.
25. Cherkupally R, Amballa H Reddy BN. In vitro antagonistic activity of Trichoderma species against Fusarium oxysporum f.sp. melongenae. Int J Appl Agric Res 2017;12:87-95.
26. Yang X, Guo P, Li M, Li H, Hu Z, Liu X, et al. Optimization of culture conditions for amoxicillin degrading bacteria screened from pig manure. Int J Environ Res Public Health 2020;17:1973. [CrossRef]
27. Dutta D, Das, MD. Effect of C/N ratio and microelements on nutrient dynamics and cell morphology in submerged fermentation of Aspergillus giganteus MTCC 8408 using Taguchi DOE. 3 Biotech 2017;7:34. [CrossRef]
28. Dutta D, Das MD. Biosynthesis of low molecular weight antifungal protein from Aspergillus giganteus in batch fermentation and in-vitro assay. Biocontrol Sci 2018;23:41-51. [CrossRef]